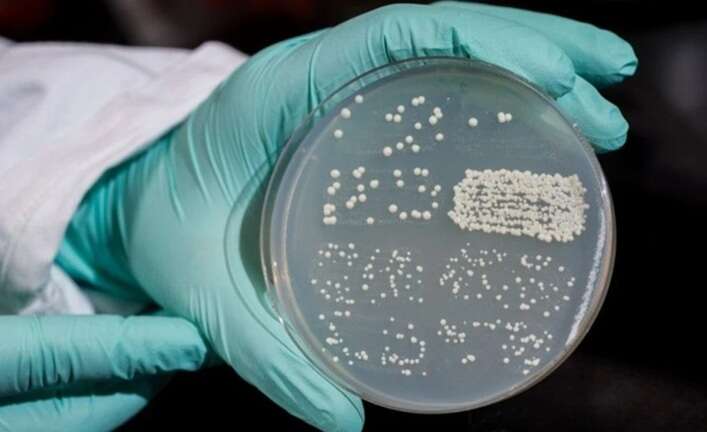
ᒺ  :

ВООЗ б’є на сполох: Грибкові інфекції стають смертельно небезпечними
Читать на русском

ВООЗ б’є на сполох: Грибкові інфекції стають смертельно небезпечними
ВООЗ б’є на сполох: Грибкові інфекції стають смертельно небезпечними
Грибкові інфекції стають небезпечно смертельними – ВООЗ б’є на сполох: смертність від деяких штамів сягає 88%.
За 10 років розроблено лише 4 нові препарати проти мікозів, але вони не завжди дієві. Кількість небезпечних грибків зросла за 20 років до 750 видів.
Науковці закликають невідкладно інвестувати в розробку нових медикаментів.
Теги: інфекціїИнфекцииВОЗВООЗ
Коментарі:
comments powered by DisqusЗагрузка...
Білий дім звинуватив демократів у шатдауні, представивши їх у вигляді привидів на відео до Геловіну
3
Співака-путініста Лепса терміново госпіталізували з важким отруєнням після концерту у Владивостоці
3
Наші опитування
Чи вірите ви, що Дональд Трамп зможе зупинити війну між Росією та Україною?
Показати результати опитування
Показати всі опитування на сайті
Показати результати опитування
Показати всі опитування на сайті
